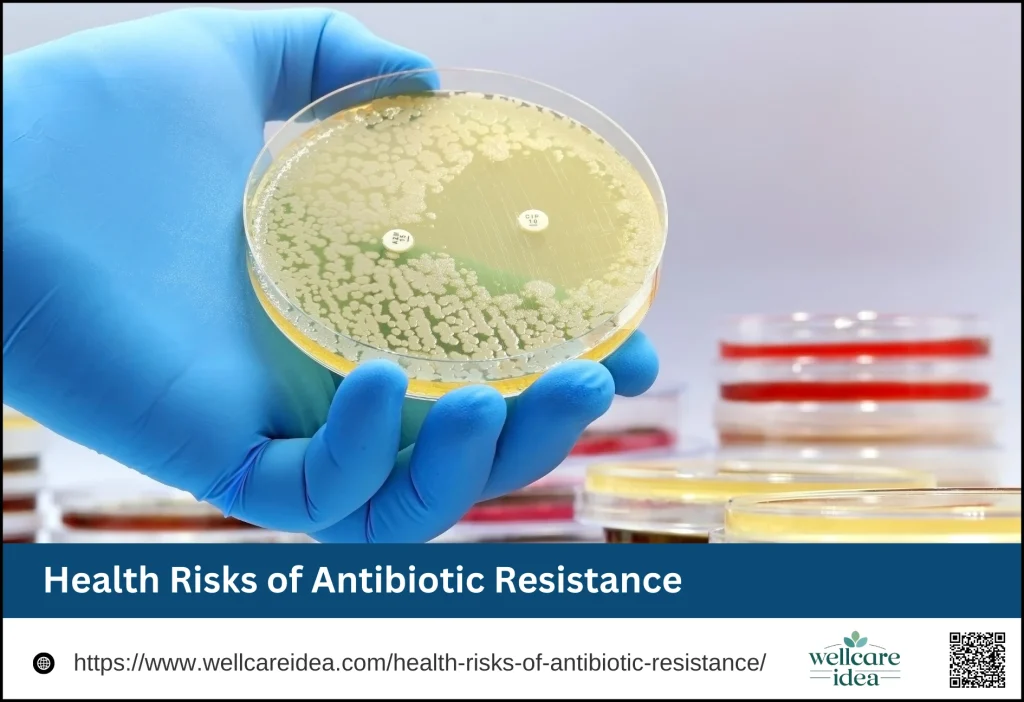
Health Risks of Antibiotic Resistance

What is Antibiotic Resistance
Bacteria are evolving organisms that naturally adapt to their environments to survive. Antibiotic resistance occurs when these germs develop the ability to defeat the drugs designed to kill them. Instead of being destroyed, the bacteria survive and continue to grow, rendering standard medications ineffective. This resistance is often encoded by specific genes that can be transferred between different types of bacteria, allowing the trait to spread rapidly 1 The emergence of these resistant strains is a natural phenomenon, but it is being dangerously accelerated by the misuse and overuse of medications in humans and animals, creating a global health crisis where common infections are becoming increasingly difficult to treat.
Health Risks of Antibiotic Resistance
1. Treatment Failure and Persistent Infection
When first-line drugs lose their power, the most immediate consequence is that the infection does not go away. Patients experience persistent infections that the body cannot clear, leading to a cycle of illness that is difficult to break. This persistence is a major driver of relapsing infections, where a patient may seem to improve temporarily, only to fall ill again because the bacteria were not fully eradicated 2 Unlike susceptible bacteria that are quickly killed, resistant strains survive the initial treatment, leading to ongoing health issues that require repeated medical intervention.
2. Increased Severity of Illness
Infections caused by resistant bacteria often result in more severe sickness compared to those caused by non-resistant strains. Because the bacteria are not checked by standard treatments, they can multiply unchecked, leading to more intense symptoms and a deeper impact on the body’s systems 3This increased virulence means that what might have once been a mild infection can rapidly escalate into a serious condition, as the pathogen overwhelms the body’s defenses before effective alternative treatments can be found 4
3. Higher Rates of Mortality
The inability to treat infections effectively leads to a significant rise in death rates. Global estimates indicate that over 1.2 million deaths were directly attributable to antimicrobial resistance in 2019 alone 5 Without urgent action, projections suggest that by the year 2050, resistant infections could kill as many as 10 million people annually, surpassing deaths from cancer 2 This underscores that resistance is not just a medical nuisance but a fatal threat to global populations.
4. Prolonged Hospitalization and Recovery Times
Patients infected with resistant superbugs require significantly more time in medical care to recover. Because standard pills do not work, doctors must try multiple alternative treatments, leading to longer hospital stays and extended recovery periods 6 This extension of care places a heavy burden on healthcare systems and increases the economic costs for patients and hospitals alike, with excess length-of-stay costs reaching millions in some regions 7
5. Limited or Non-Existent Treatment Options
As bacteria evolve, we are seeing a growing shortage of effective therapies. In some alarming cases, doctors are encountering infections that are resistant to nearly all known antibiotics, leaving patients with virtually no treatment options 8 The pipeline for new antibiotics is not keeping pace with the speed of bacterial evolution, meaning we face a future where common infections could once again become untreatable and fatal 8
6. Increased Risk of Complications (e.g., Sepsis, Organ Failure)
When an infection cannot be controlled quickly, it can spread to the bloodstream and cause life-threatening complications like sepsis. Sepsis is a severe reaction that can lead to rapid organ dysfunction and failure 9 Resistance complicates this further because the delay in finding the right drug allows the infection to progress to this critical stage, where the risk of identifying the wrong pathogen or using inappropriate therapy increases significantly 10
7. Use of More Toxic “Last-Resort” Medications
When standard antibiotics fail, physicians are forced to rely on “last-resort” drugs that are often older, more expensive, and more dangerous. These alternative medications frequently come with severe side effects, such as kidney failure (nephrotoxicity) or liver damage, which can be permanent 11 The use of these stronger drugs is a desperate measure that trades one risk for another, increasing the likelihood of toxicity in the patient 11
8. Compromised Safety of Medical Procedures
Modern medicine relies heavily on the ability to prevent infection during invasive procedures. Surgeries, organ transplants, and cancer treatments like chemotherapy all depend on effective antibiotics to keep patients safe; without them, the risk of life-threatening infections during these procedures becomes unmanageably high 12 Resistance threatens to undo decades of medical progress, making routine operations dangerous once again 13
9. Spread of Untreatable “Superbugs”
Resistant bacteria, often called “superbugs,” do not stay isolated; they spread easily within communities and hospitals. Strains like MRSA (Methicillin-resistant Staphylococcus aureus) and multidrug-resistant tuberculosis are now found globally, putting even healthy individuals at risk of catching an untreatable illness 3 These pathogens are highly transmissible, creating outbreaks that are difficult to contain and control.
10. Increased Vulnerability for Immunocompromised Patients
Individuals with weakened immune systems are in the greatest danger. Patients undergoing cancer treatment, those with HIV/AIDS, or organ transplant recipients rely on antibiotics to survive common exposures, but resistance makes their infections much harder to treat 14 For these vulnerable groups, a resistant infection is often fatal because their own immune systems cannot fight off the bacteria while the drugs fail to work 15